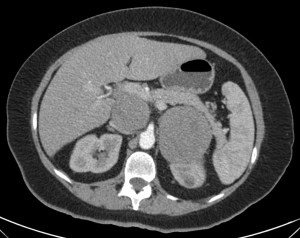
MX

Paciente de 56 años en el que se descubre una masa suprarrenal derecha de 4,1 x 2.8 cm aprox., al realizar un TC de abdomen por otro motivo. Se procede al diagnóstico y caracterización de dicha lesión en la glándula suprarrenal derecha.
¿Cómo se hace? Veámos un ejemplo.




Calculamos la Fórmula WASHOUT, optaremos por la absoluta.
(PORTAL – TARDÍA / PORTAL – Sin CONTRASTE) x 100% = (54,8 – 12,1 / 54,8 – 2,08) x 100 = 80,7 %
El porcentaje de lavado es > 60%. Todos estos hallazgos establecen el diagnóstico de ADENOMA SUPRARRENAL.
INCIDENTALOMA ADRENAL:
Las glándulas suprarrenales se localizan por encima y adyacente a los riñones y en posición supero interna, rodeadas por grasa y bien circunscritas a las fascias Gerota y de Zucker-kandl. Tienen una morfología de V o Y y pesan alrededor de 4,5 gr. La medula constituye el 10%, secreta Adrenalina y Noradrenalina y procede del ectodermo de la cresta neural. La corteza constituye el 90% y procede del mesodermo, se divide en Glomerulosa, secreta Mineralcorticoides (Aldosterona), y en Fascicular-Reticular, secretan Glucocorticoides y Andrógenos, bajo dependencia de la ACTH.
Las lesiones más comunes en las glándulas son el adenoma y las metástasis, siendo el adenoma la patología más frecuente en pacientes sin antecedentes de neoplasia. Otras patologías que podemos encontrar son feocromocitomas, carcinomas, linfomas, quistes, pseudoquistes, mielolipomas, hemangiomas, hematomas, etc. En caso de sospechar lesiones hiperfuncionantes, como el aldosteronoma o el feocromocitoma, se debe realizar además un analisis bioquímico para diagnósticar su exceso y luego TC o RM para la localización.
Las glándulas suprarrenales pueden se asiento de numerosas patologías, hasta en el 9% de la población encontramos patología adrenal. Un nódulo suprarrenal puede ser descubierto de manera incidental, en el 80-90% son unilaterales, y más hoy en día con el desarrollo y el mayor uso de la TC y la RM, técnicas que nos permiten no solo el hallazgo sino también la caracterización de las lesiones en benignas y malignas. La caracterización de las masas suprarrenales se realiza mediante dos parámetros: Contenido lípido de la lesión y la cinética de realce tumoral. El análisis histológico ha demostrado que el contenido lipído de los adenomas (secretantes y no secretantes) es mucho más importante que en las lesiones de tipo tumoral maligno. Una semiología, basada en esta composición histoquímica, ha sido desarrolla para TC y RM.
TECNICAS DE ESTUDIO:
Semiología TC
Los adenomas presentas densidades tomográficas bajas calificadas como pseudo-lipídicas, con valores de atenuación que pueden estar próximos a las 0 UH o incluso valores negativos. La medida de la densidad necesita una técnica estricta: Cortes finos para evitar el artefacto de volumen parcial + colocación del ROI que cubra dos tercios de la lesión evitando las zonas periféricas. Esta técnica presenta una S 71% y E 98% (Boland et al) para adenomas que presentan menos de 10UH.
El problema se plantea cuando el adenoma contiene poca cantidad de grasa (29% de los casos) . Para ello, se ha descrito una semiología complementaria, el estudio de cinética de realce y lavado (Wash out). Los adenomas se impregnan de contraste y lavan rápidamente. ¿Por qué? Por su arquitectura vascular, que es densa y no permite la extravasación de contraste al intersticio. Todo lo contrario en lesiones malignas (también infecciosas e inflamatorias), de arquitectura anárquica que permite la extravasación y por ello tardan en lavarse.
Fórmulas:
Cuando el porcentaje de lavado es > 60% en Absoluto y > 40% en Raltivo = Adenoma
Resonancia Magnética:
Se usarán secuencias que permitan diferenciar el contenido lipídico de la lesión. Se usan secuencias que utilizan la diferencia de resonancia de los protones de agua y de grasa. Para cada nivel de corte se adquieren dos imágenes, (con el mismo tiempo de repetición pero con eco diferente). Los ecos son elegidos de manera que los protones del hidrógeno, presente en el agua y en la grasa, se encuentren alternativamente en fase y fuera de fase. La técnica que se usa más frecuentemente es por tanto esa, la del cambio químico o «chemical Shift», que consiste en dos adquisiciones en T1 con tiempos de eco diferente. La grasa de un adenoma mostrará una baja intensidad de señal en oposición de fase (cae más de un 20%).
ALGORITMO DIAGNÓSTICO:
Lo ideal sería hacer un TC sin contraste y analizar las caracteríticas de la lesión. Si es una lesión homogénea, pequeña (<4 cm) y con contenido lipídico (<10 UH) los hallazgos son muy E para adenoma. En caso contrario, realizamos estudio con contraste (Vacío + Portal + Tardío a los 7-10 min), medimos la densidad con ROI y aplicamos las fórmula Washout.
Es interesante señalar que los adenomas con poco contenido en lípidos (tienen más de 10 UH) se comportan y lavan de la misma manera que los que sí tienen alto contenido y que además, la aplicación de la fórmula Washout es independiente a la cantidad de contraste inyectado.
PATOLOGÍA de las GLÁNDULAS SUPRARRENALES:
ADENOMA:
Se encuentran hasta en el 3% de las necropsias, constituyen la mayoría de las veces un hallazgo incidental y son pequeños, unilaterales, no funcionantes y en pacientes no sintomáticos. Una mínima cantidad son hiperfuncionantes, responsables de cuadros como el Sd. de Cushing (exceso de glucocorticoides) o el Sd. de Conn (hiperaldosteronismo)
En TC son lesiones inferiores a 3 cm, homogéneas, bien delimitadas y de baja atenuación por el contenido graso que lo componen. Con contraste, como dijimos anterioremente, captan y lavan rápidamente.
METÁSTASIS:
Es la lesión maligna más frecuente en las suprarrenales. Constituye el cuarto sitio más frecuente de metátasis en el cuerpo, a pesar de su pequeño tamaño. Suelen proceder de pulmón, máma, riñón, intestino, páncreas, melanoma. Suelen ser bilaterales, más grandes que los adenomas y con contornos irregulares. TC sin civ > 10 UH, tardan en lavar (Washout < 50%) y no tienen una caida de señas significativa en T1.
Algunos adenomas atípicos pueden comportarse así, por ello a veces recurrimos a PET y Biopsia.

FEOCROMOCITOMA:
Tumor poco frecuente, secreta catecolaminas, proviene de la médula suprarrenal (ectodermo). Provoca cefalea, ansiedad, palpitaciones fruto del exceso de A y NA. El diagnóstico pasa por la clínica, el laboratorio y la imagen. Son pequeños (2-5 cm) e hipervasculares, pueden tener densidad líquido en su interior y quistes. En RM son hipointensos en T1 y marcadamente hiperintensos en T2. La solución pasa por la extirpación quirúrgica.
Se le llama el tumor del 10%:
- 10% bilaterales
- 10% extraadrenales
- 10% en niños
- 10% malignos asociados síndrome con los MENs, Von Hippel Lindau y Neurofibromatosis.




CARCINOMA SUPRARRENAL:
Tumor raro, procede de la corteza y se da en personas de edad avanzada (70 – 80 años). Hiperfuncionante en la mayoría de casos como Sd de Cushing. Tumor grande de entre 6 – 20 cm, heterogéneos en TC y RM con áreas de necrosis y hemorragia (hipodensos en TC, hiperintensas en T1 y T2 en RM), con contraste iv refuerzan de forma nodular y el lavado es lento. Calcifican el 30%, pueden invadir órganos en proximidad, vena renal y cava y metástasis a distancia, por ejemplo a pulmón.
MIELOLIPOMA:
Tumor raro, compuesto de tejido adiposo maduro y hematompoiético. Su característica principal es la presencia de grasa macroscópica (<10 UH), que es lo que determina también su hallazgo en TC y RM, aunque se pueden observar áreas con mayor densidad en TC por el tejido hematopoiético.


LINFOMA:
Poco frecuente, la mayoría de las veces es no-Hodgkin. Se diagnostica incidentalmente y se ve en TC y RM un engrosamiento difuso o nodular y en un 50% son bilaterales.
LESIONES QUÍSTICAS:
Poco frecuentes, se observan en personas de 30 – 50 años y suelen producir clínica de dolor y masa cuando crecen. Hay diversos tipos y se suelen ver hipodensos en TC, hipointensos en T1 e hiperintensos en T2, sin refuerzo de contraste ni componente sólido.
HEMATOMAS:
Tras traumatismo, en especial cuando se lesiona el lóbulo hepático derecho y este comprime la suprarrenal contra la columna. También pueden verse en el contexto de trombosis de la vena suprarrenal, hipotension o shock. en TC, espontáneamente hiperdenso sin refuerzo de contraste. En RM, lo mas S y E, se observan las variaciones de intensidad según la evolución temporal de la sangre; en general hiperintensa en T1 e hipointensa en T2 sin refuerzo tras contraste.
Bibliografía
http://www.webcir.org/revistavirtual/articulos/marzo14/argentina/arg_faardit_esp_a.pdf
http://www.scielo.cl/scielo.php?pid=S0717-93082009000100005&script=sci_arttext
The Radiology Assistant – Adrenals.


Deja un comentario